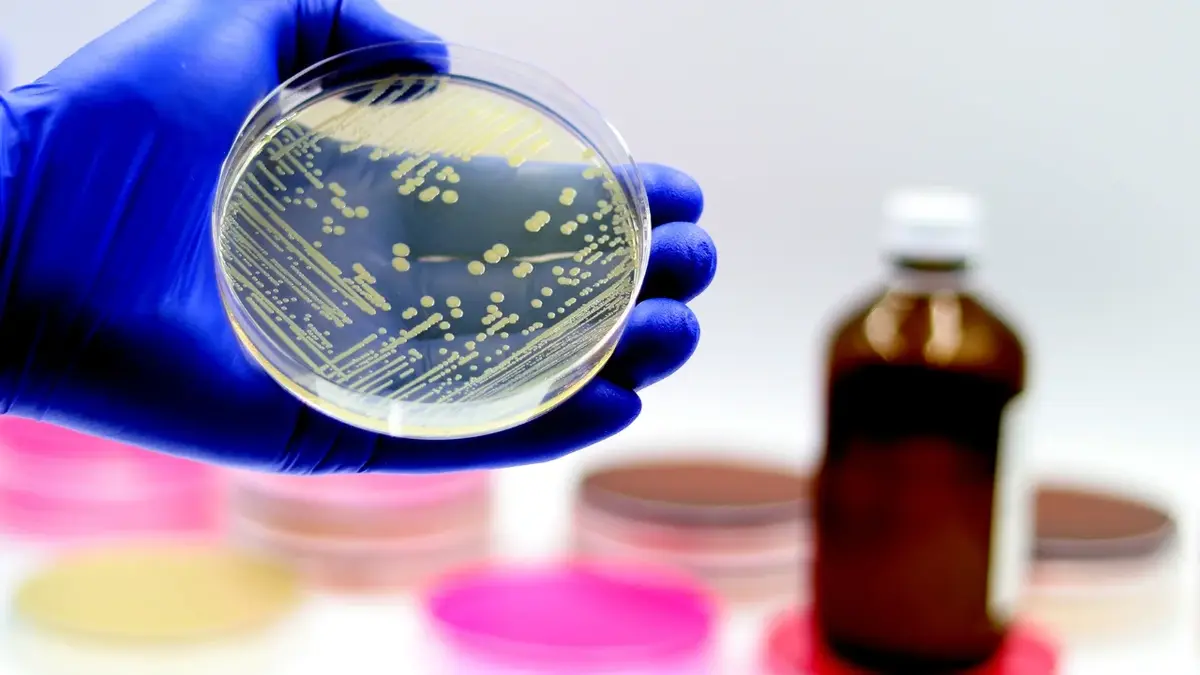

Gronkowiec złocisty - co musisz wiedzieć?
Do przeczytania w ok. 2 min.
Co to jest gronkowiec złocisty?
Gronkowiec złocisty, znany również jako Staphylococcus aureus, jest jednym z najbardziej niebezpiecznych gatunków gronkowców. Bakteria ta może kolonizować błonę śluzową i skórę człowieka, powodując różnego rodzaju infekcje. Gronkowiec złocisty jest odporny na wiele antybiotyków, co utrudnia skuteczne leczenie infekcji.
Jak dochodzi do zakażenia gronkowcem złocistym?
Infekcje gronkowcem złocistym mogą występować na skórze, w ranach, w jamie ustnej, gardle, nosie, a także w innych częściach ciała. Bakteria może przenosić się drogą kontaktową, przez bezpośrednią styczność z zakażoną osobą lub przedmiotem. Gronkowiec złocisty może również przenikać do organizmu przez uszkodzoną skórę lub błony śluzowe.
Jakie są objawy zakażenia gronkowcem złocistym?
Objawy zakażenia gronkowcem złocistym mogą być różnorodne i zależą od lokalizacji infekcji. W przypadku infekcji skórnych, mogą występować ropnie, czyraki, czy zapalenie mieszków włosowych. Infekcje górnych dróg oddechowych mogą objawiać się bólem gardła, kaszlem, katarzem, a także gorączką. Gronkowiec złocisty może również powodować infekcje układu moczowego, zapalenie płuc, zapalenie wsierdzia oraz inne poważne schorzenia.
Czego nie lubi gronkowiec złocisty?
Gronkowiec złocisty nie lubi czystości i higieny. Dlatego ważne jest, aby utrzymywać odpowiednią higienę osobistą, regularnie myć ręce, dezynfekować powierzchnie i przedmioty oraz unikać kontaktu z osobami zakażonymi. W przypadku ran i skaleczeń, należy je odpowiednio oczyszczać i zabezpieczać, aby zapobiec zakażeniu gronkowcem złocistym.
Jak zapobiegać zakażeniu gronkowcem złocistym?
Aby zapobiec zakażeniu gronkowcem złocistym, warto przestrzegać kilku podstawowych zasad higieny:
- Regularnie myj ręce wodą i mydłem przez co najmniej 20 sekund.
- Unikaj dotykania twarzy, nosa i ust nieumytymi rękami.
- Dezynfekuj powierzchnie i przedmioty, które często dotykasz, takie jak klamki, telefony, klawiatury.
- Nie dziel się osobistymi przedmiotami, takimi jak szczoteczka do zębów, ręczniki czy ubrania.
- Zachowaj czystość w miejscach publicznych, takich jak toalety, baseny czy siłownie.
Gronkowiec Złocisty - bezpieczeństwo i higiena w domu
Gronkowiec złocisty to niebezpieczna bakteria, która może powodować różnego rodzaju infekcje.
Jej obecność w organizmie może być utajona i nie dawać żadnych objawów przez wiele lat. W celu zapobiegania zakażeniu gronkowcem złocistym, należy utrzymywać odpowiednią higienę osobistą, regularnie myć ręce, dezynfekować powierzchnie i przedmioty oraz unikać kontaktu z osobami zakażonymi. W przypadku wystąpienia objawów infekcji, należy jak najszybciej skonsultować się z lekarzem, aby rozpocząć odpowiednie leczenie.